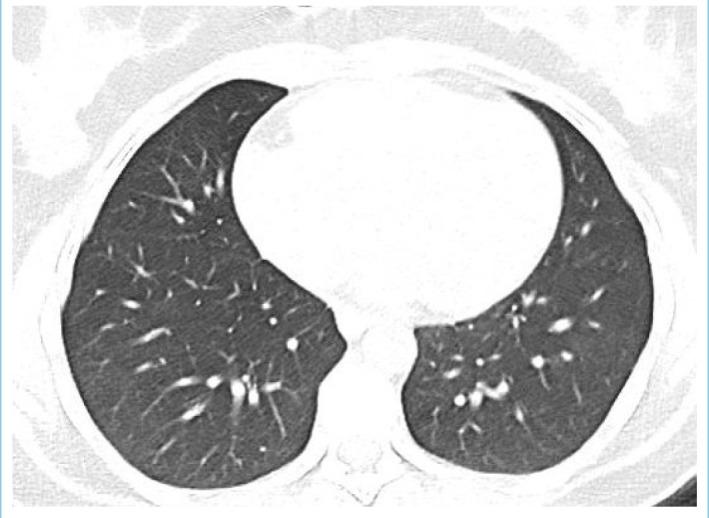
https://cdn.ncbi.nlm.nih.gov/pmc/blobs/5a23/11128696/180b8d183486/SEMB-58-131-g005.jpg

一名新冠肺炎患者的展神经麻痹:病例报告
Abducens Nerve Palsy in a Patient with COVID-19: A Case Report.
作者信息
Tata Gulten, Isik Sahin, Diktas Husrev, Genc Gencer, Bulut Serpil
机构信息
Department of Neurology, University of Health Sciences Türkiye, Sisli Hamidiye Etfal Training and Research Hospital, Istanbul, Türkiye.
Department of Neurology, Batman Training and Research Hospital, Batman, Türkiye.
出版信息
Sisli Etfal Hastan Tip Bul. 2024 Apr 5;58(1):131-134. doi: 10.14744/SEMB.2023.55491. eCollection 2024.
Numerous neurological manifestations associated with COVID-19 have been reported. However, abducens nerve palsy (ANP) associated with COVID-19 is very rare and mostly related to accompanying respiratory symptoms. Here we present a 29-year-old woman with unilateral ANP manifesting with diplopia and positive SARS-CoV-2 S antibodies, which were checked later. On admission, she had signs of viral pneumonia in thorax CT without any respiratory symptoms. Her cranial neuroimaging revealed no abnormality. Following treatment with favipiravir 2x1600 mg loading dose and then 2x600mg daily maintenance, dexamethasone 8 mg/day and enoxaparin 6000 IU/day, her CT findings recovered completely whereas her ANP only partially resolved. One week after the end of COVID-19 treatment, she also developed Herpes simplex keratitis which was successfully treated with valacyclovir. It should be kept in mind that isolated abducens nerve palsy may be the only finding of COVID-19 cases without any respiratory symptoms.
已有许多与新冠病毒病(COVID-19)相关的神经学表现的报道。然而,与COVID-19相关的外展神经麻痹(ANP)非常罕见,且大多与伴随的呼吸道症状有关。在此,我们报告一名29岁女性,出现单侧ANP,表现为复视,后来检测出严重急性呼吸综合征冠状病毒2(SARS-CoV-2)S抗体呈阳性。入院时,她胸部CT有病毒性肺炎迹象,但无任何呼吸道症状。她的头颅神经影像学检查未发现异常。在用法匹拉韦2×1600mg负荷剂量,然后每日2×600mg维持剂量、地塞米松8mg/天和依诺肝素6000IU/天治疗后,她的CT表现完全恢复,而她的ANP仅部分缓解。COVID-19治疗结束一周后,她还患上了单纯疱疹性角膜炎,用伐昔洛韦成功治疗。应记住,孤立的外展神经麻痹可能是无任何呼吸道症状的COVID-19病例的唯一表现。